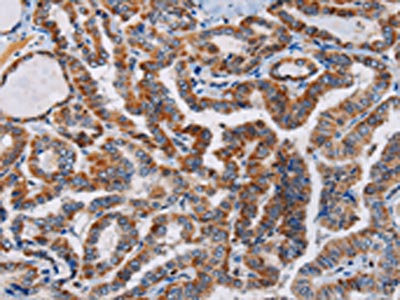

PLCB3 Antibody
-
中文名稱:PLCB3兔多克隆抗體
-
貨號:CSB-PA906272
-
規格:¥1100
-
圖片:
-
The image on the left is immunohistochemistry of paraffin-embedded Human thyroid cancer tissue using CSB-PA906272(PLCB3 Antibody) at dilution 1/40, on the right is treated with synthetic peptide. (Original magnification: ×200)
-
Gel: 6%SDS-PAGE, Lysate: 40 μg, Lane 1-2: A431 cells, PC3 cells, Primary antibody: CSB-PA906272(PLCB3 Antibody) at dilution 1/200, Secondary antibody: Goat anti rabbit IgG at 1/8000 dilution, Exposure time: 3 minutes
-
-
其他:
產品詳情
-
Uniprot No.:
-
基因名:
-
別名:1 phosphatidylinositol 4 5 bisphosphate phosphodiesterase beta 3 antibody; 1-phosphatidylinositol-4 antibody; 5-bisphosphate phosphodiesterase beta-3 antibody; Phosphoinositide phospholipase C antibody; Phosphoinositide phospholipase C-beta-3 antibody; Phospholipase C beta 3 antibody; Phospholipase C beta 3 (phosphatidylinositol specific) antibody; Phospholipase C-beta-3 antibody; PLC beta 3 antibody; PLC-beta-3 antibody; Plcb3 antibody; PLCB3_HUMAN antibody
-
宿主:Rabbit
-
反應種屬:Human,Mouse,Rat
-
免疫原:Synthetic peptide of Human PLCB3
-
免疫原種屬:Homo sapiens (Human)
-
標記方式:Non-conjugated
-
抗體亞型:IgG
-
純化方式:Antigen affinity purification
-
濃度:It differs from different batches. Please contact us to confirm it.
-
保存緩沖液:-20°C, pH7.4 PBS, 0.05% NaN3, 40% Glycerol
-
產品提供形式:Liquid
-
應用范圍:ELISA,WB,IHC
-
推薦稀釋比:
Application Recommended Dilution ELISA 1:1000-1:2000 WB 1:200-1:1000 IHC 1:50-1:200 -
Protocols:
-
儲存條件:Upon receipt, store at -20°C or -80°C. Avoid repeated freeze.
-
貨期:Basically, we can dispatch the products out in 1-3 working days after receiving your orders. Delivery time maybe differs from different purchasing way or location, please kindly consult your local distributors for specific delivery time.
-
用途:For Research Use Only. Not for use in diagnostic or therapeutic procedures.
相關產品
靶點詳情
-
功能:The production of the second messenger molecules diacylglycerol (DAG) and inositol 1,4,5-trisphosphate (IP3) is mediated by activated phosphatidylinositol-specific phospholipase C enzymes.
-
基因功能參考文獻:
- Data suggest that 300-residue C-terminal domain of PLCB3 promotes adsorption to phospholipid monolayer/membrane bilayer and is required for spatial organization/adsorption of PLCB3 on membrane surface; defects in phosphatidylinositol 4,5-bisphosphate (PIP2) hydrolysis alter monolayer adsorption, thus, suggesting role of active site in this process; PLCB3 is preferentially adsorbed to region of bilayer enriched with PIP2. PMID: 28945350
- These results indicate that the mechanism by which Galphaq and PLC-beta3 mutually regulate each other is far more complex than a simple, two-state allosteric model and instead is probably kinetically determined. PMID: 28842497
- We propose that unliganded PLC-beta exists in equilibrium between a closed conformation observed in crystal structures and an open conformation where the PH domain moves away from the EF hands. Therefore, intrinsic movement of the PH domain in PLC-beta modulates Gbetagamma access to its binding site. PMID: 27002154
- the MCP1-induced cortactin phosphorylation is dependent on PLCb3-mediated PKC activation, and siRNA-mediated down-regulation of either of these molecules prevents cortactin interaction with WAVE2 PMID: 26490115
- membranes are integral for the activation of PLC-beta isozymes by diverse modulators. PMID: 25193662
- the M3 muscarinic receptor maximizes the efficiency of PLCbeta3 signaling beyond its canonical role as a guanine nucleotide exchange factor for Galpha. PMID: 24596086
- This study provides an understanding of the structural basis for the PDZ-mediated NHERF1-PLCbeta3 interaction that could prove valuable in selective drug design against CXCR2-related cancers. PMID: 24642259
- PLCbeta3 is enriched in the cytosol. PMID: 23006664
- phospholipase C-beta3 structure reveals the role of the its distal C-terminal domain PMID: 23377541
- Stromal cell-derived factor-1 signaling via the CXCR4-TCR heterodimer uses PLC-beta3 to activate the Ras-ERK pathway and increase intracellular calcium ion concentrations PMID: 21705626
- Data demonstrate that PLCB3, by regulating intracellular calcium transients, plays a relevant role in amplifying the expression and release of IL-8, the major chemokine recruiting neutrophils in CF airway lungs. PMID: 21411730
- Activation of hPLCbeta3 by U73122 required covalent modification of cysteines as evidenced by the observation that enzyme activation was attenuated by thiol-containing nucleophiles, l-cysteine and glutathione. PMID: 21266572
- Studies indicate that the complex between the effector protein phospholipase C-beta3 (PLC-beta3) and its activator, Galpha(q), suggests that several effectors independently evolved a structurally similar helix-turn-helix segment for G protein recognition. PMID: 21304157
- study describe the structure of PLC-beta3 in an activated complex with Galphaq, which together with supporting biochemical and physiological analyses reveals its mechanism of transmembrane signaling PMID: 20966218
- PLC beta 3 and PLC beta 1 bind to calmodulin PMID: 12821674
- findings demonstrated that G-protein-activated phospholipase C-beta interacts with cell polarity proteins Par3 and Par6 to form protein complexes and to mediate downstream signal transduction PMID: 15782111
- reduced Ca(2+) signaling in high glucose cannot be explained by reduced Ca(2+) stores but is due to conventional PKC-dependent phosphorylation and inactivation of PLC-beta(3) PMID: 15998840
- Homodimerization of PLC-beta3 and PLC-beta1 isoenzymes was observed but heterodimerization of these isoenzymes was not detected. PMID: 16763092
- Fission of transport carriers at the trans-Golgi network is dependent on specifically PLCbeta3, which is necessary to activate PKCeta and PKD in that Golgi compartment, via diacylglycerol production. PMID: 17492941
- both negative crosstalk from the cAMP/PRKA pathway and a negative feedback loop in the oxytocin/G protein/PLCB pathway involving PRKC operate in myometrial cells PMID: 18322273
- PLCbeta3 may provide a selective target for inhibiting Ca(2+) responses to mediators of inflammation, including C5a, UDP, PAF, and LPA PMID: 18411281
- VEGF, specifically through VEGFR2, induces phosphorylation of two serine residues on PLCbeta3. PMID: 19295129
顯示更多
收起更多
-
亞細胞定位:Cytoplasm. Membrane. Nucleus.
-
數據庫鏈接:
Most popular with customers
-
-
YWHAB Recombinant Monoclonal Antibody
Applications: ELISA, WB, IHC, IF, FC
Species Reactivity: Human, Mouse, Rat
-
Phospho-YAP1 (S127) Recombinant Monoclonal Antibody
Applications: ELISA, WB, IHC
Species Reactivity: Human
-
-
-
-
-